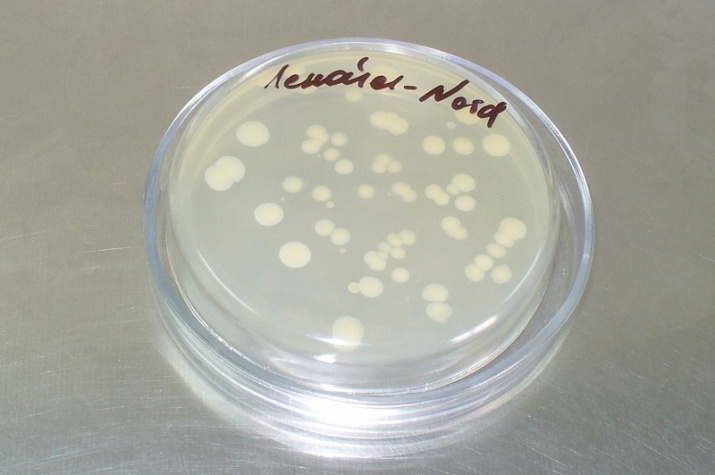

Ученые Уфимского Института биологии РАН совершили открытие мирового значения. Их достижение вошло в 18 главных результатов Российской академии наук за 2016 год, о которых доложили президенту России Владимиру Путину. Это очень престижно как для Уфимского Института биологии, так и для Башкирии в целом.
Уфимские биологи обнаружили бактерию, способную утилизировать нефть при низких положительных температурах, что очень актуально для российского климата. Это совершенно новый вид микроорганизмов, ранее никем не описанный.
— Развитие нефтегазового комплекса негативно воздействует на все экосистемы, — говорит директор Уфимского Института биологии РАН, действительный член Русского географического общества, председатель природоохранительной комиссии РО РГО в РБ Василий Мартыненко. — Добыча, транспортировка, переработка и использование нефти и нефтепродуктов приводят к загрязнению окружающей среды. Если воздух и вода самоочищаются достаточно быстро, то почва восстанавливается гораздо дольше. Она накапливает токсические вещества, в результате чего резко снижается или полностью утрачивается её плодородие. Поскольку наилучшая температура для разложения нефти — это плюс 25-30оС, то в регионах с холодным и умеренным климатом самоочищение почвы продолжается очень долго, в течение десятилетий. А именно в северных районах и сосредоточена значительная часть нефтедобывающих предприятий России. Поэтому для таких территорий, в том числе и для нашей республики, актуальным является проведение очистных работ с использованием микроорганизмов, которые обеспечивают полную переработку нефти и нефтепродуктов до углекислого газа и воды и способны «работать» при пониженных температурах.
В 2012 году сотрудники Уфимского Института биологии Российской академии наук в нефтезагрязненной почве Туруханского района Красноярского края обнаружили бактерию, разлагающую нефть и нефтепродукты при низких положительных температурах (4-10оС). Но тогда смогли установить только её родовую принадлежность, поскольку определить до вида микроорганизм очень сложно. Способ очистки нефтезагрязненных грунтов при низких положительных температурах с помощью этой бактерии запатентован в Российской Федерации.
На основе культуры этой бактерии специалисты Уфимского Института биологии РАН под руководством заведующего лабораторией биотехнологий доктора биологических наук, профессора Олега Логинова разработали и запатентовали биопрепарат для разложения нефти на углекислый газ и воду. Биопрепарат-нефтедеструктор называется «Ленойл»® – NORD, он предназначен для биологической обработки загрязненных нефтью почв, грунтов, водных поверхностей и ускорения разложения нефти, восстановления продуктивности рекультивируемых почв и очистки водных объектов в условиях умеренного климата.
В 2016 году уфимским биологам удалось определить эту бактерию до вида. Это оказался новый вид микроорганизмов, ранее нигде в мире не описанный. Он получил название Pseudomonas turukhanskensis в честь географического источника выделения — Туруханского района Красноярского края, а его типовой представитель помещен на хранение во Всероссийскую коллекцию микроорганизмов и в Испанскую коллекцию типовых культур. Заслуги сотрудников Уфимского Института биологии РАН получили мировое признание и были отмечены в отчетном докладе Президента Российской академии наук академика Владимира Фортова за 2016 год. Башкирские ученые сделали отличный подарок к Году экологии в России!
«Электрогазета» поговорила с профессором Олегом Логиновым.
— То, что мы попали в ежегодный доклад Президента Российской академии наук, где он рассказывает о самых наукоёмких разработках, выполненных на мировом уровне, очень приятно и почетно. Также приятно то, что наша лаборатория не только показала фундаментальный результат, но и сразу выпустила продукцию, которая востребована.
Сейчас наш биопрепарат активно производится и реализуется. У нас покупают его компании, добывающие и транспортирующие нефть в северных районах нашей страны.
Первым автором нашей разработки стала старший научный сотрудник лаборатории, кандидат биологических наук Татьяна Коршунова. В создании биопрепарата активное участие принимал ведущий научный сотрудник, доктор биологических наук Сергей Четвериков.
Прикладной аспект открытия нового вида бактерий в том, что появился биопрепарат, выпускаемый в промышленных масштабах, который способен ликвидировать нефтезагрязнения при низких положительных температурах. Уже при температуре +1 градус открытая нами бактерия начинает активно разлагать нефть до безвредных углекислого газа и воды. До этого в России, в США, в Японии, в Европе выпускались промышленные препараты, бактерии в которых утилизировали нефть, начиная с +15, +17 градусов. У нас в институте были более ранние разработки биопрепаратов-нефтедеструкторов. Но они тоже работали при температуре +10, +15 градусов. Если температура +9, то бактерии уже резко снижали свою активность. Поэтому наш новый биопрепарат «Ленойл»® – NORD, «работающий» даже при +1 градусе, сейчас вне конкуренции.